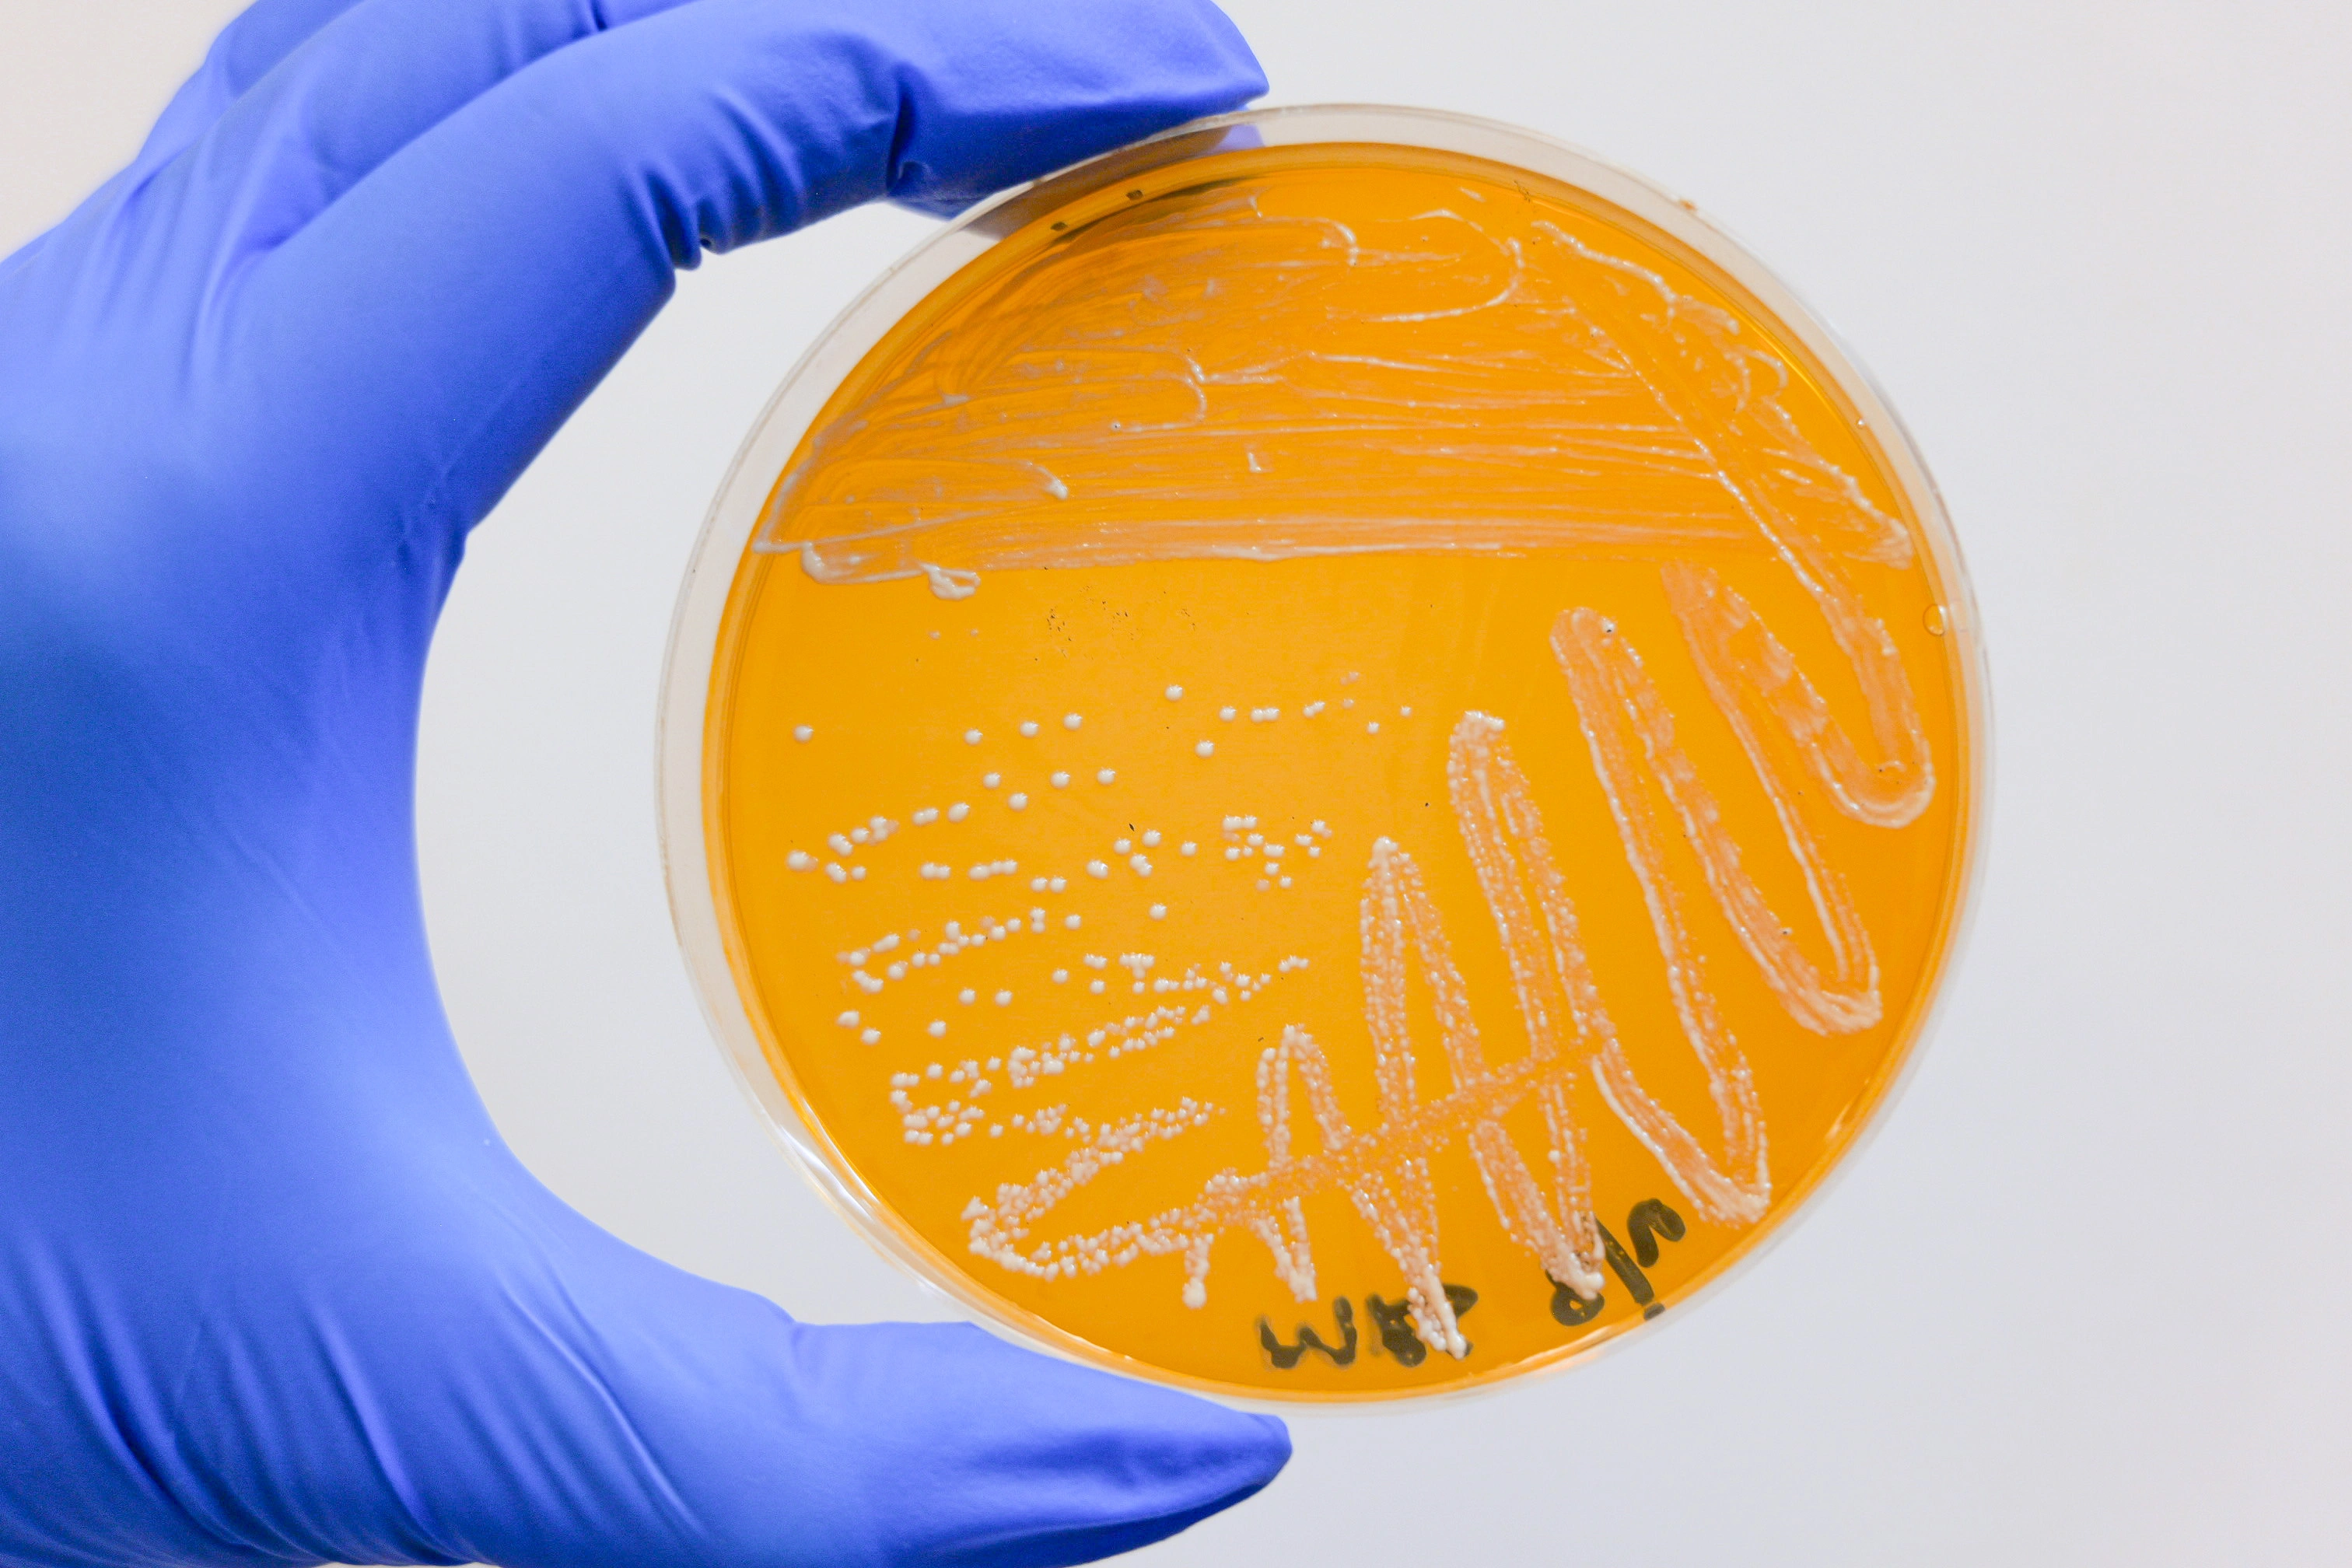
Petri dish with bacterial colonies for strain validation

Contract Fermentation
Scalable, controlled fermentation for probiotic lactic acid-producing bacteria. We combine flexibility, data-backed precision, and cGMP compliance to deliver consistent, high-quality results at any scale.
Your Fermentation Partner in Scale
ProbioFerm supports your full production journey—from inoculation through downstream processing and final product delivery. Our fermentation capabilities integrate seamlessly with our R&D and manufacturing divisions, giving you a single, trusted partner for every stage of development.
- Flexible capacity to meet pilot, mid-range, or full-scale production volumes.
- Cost efficiency through streamlined operations and optimized batch yields.
- Confidential strain protection with in-house whole genome sequencing and secure data management.
The ProbioFerm Difference
Our facilities and processes are designed for reliability, efficiency, and protection at every step. From allergen-free media to multi-point QC validation, we ensure your culture performs to expectation—batch after batch.

Allergen-Free Media
Customized, contamination-free fermentation for human and animal applications.

In-House QC & Testing
Quality verified at multiple timepoints during each batch cycle.

cGMP-Controlled Environments
Compliance-driven facilities with traceability and process documentation.
Validated Strain Integrity
Backed by genomic verification and secure data protocols.

Flexible Scale-Up
Pilot to commercial volumes without compromising quality or timelines.

Optimized Drying Methods
Multiple options to maximize CFU counts and product stability.
Fermentation Process Flow
Our controlled fermentation workflow ensures purity, consistency, and performance—every step aligned with your formulation goals.

Fermentation Capacity Tailored to Your Needs
Whether you need pilot-scale fermentation or large-volume production, our vessel range offers flexibility without sacrificing quality or efficiency.

250L
Fermentation vessel

1200L
Fermentation vessel

2000L
Fermentation vessel

5000L
Fermentation vessel
Quality and Compliance You Can Count On
Every batch follows documented SOPs and undergoes rigorous in-process and final QC checks. Our team ensures compliance with cGMP standards and provides full traceability from start to finish.
Ready to Scale Your Fermentation?
Let's discuss your next project and show you how ProbioFerm delivers precision, protection, and performance at every stage of fermentation.
Discuss Your Project